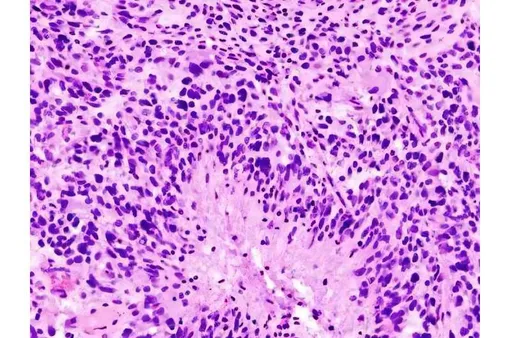
Глиобластома (гистологический слайд)

Особенность глиобластомы в том, что она не просто растет сама по себе, а перепрограммирует здоровые клетки мозга. Опухоль создает вокруг себя сложную сеть, которая питает ее, защищает и помогает распространяться.
Ученые обнаружили, что существующий препарат от ВИЧ может помочь в борьбе с глиобластомой

Ученые из Университета Макмастера и Детской больницы Торонто (SickKids) изучили, какие именно здоровые клетки мозга опухоль заставляет работать на себя. Исследование было опубликовано в журнале Neuron.
Оказалось, что все дело в олигодендроцитах. Обычно они изолируют нервные волокна, то есть обматывают отростки нейронов специальным веществом — миелином, — чтобы электрические сигналы в мозге передавались быстро и четко. Но в присутствии глиобластомы они начинают активно общаться с раковыми клетками, посылая им химические сигналы, которые укрепляют опухоль, помогают ей расти и выживать.
Сигналы от олигодендроцитов поступают к раковым клеткам через рецептор под названием CCR5. Когда исследователи в лабораторных условиях заблокировали его, рост глиобластомы значительно замедлился.
Как с этим может помочь лекарство от ВИЧ
Рецептор CCR5 давно и хорошо изучен, но в контексте совсем другой болезни — ВИЧ-инфекции. Вирус иммунодефицита использует именно этот рецептор, чтобы проникнуть в клетки иммунной системы.
Более того, фармацевты много лет назад создали лекарство, которое блокирует этот рецептор. Это препарат под названием Маравирок.
«Расшифровав, как эти клетки взаимодействуют, мы обнаружили уязвимость, которую можно атаковать препаратом, уже находящимся на рынке», — заключила профессор хирургии в Университете Макмастера Шейла Сингх.